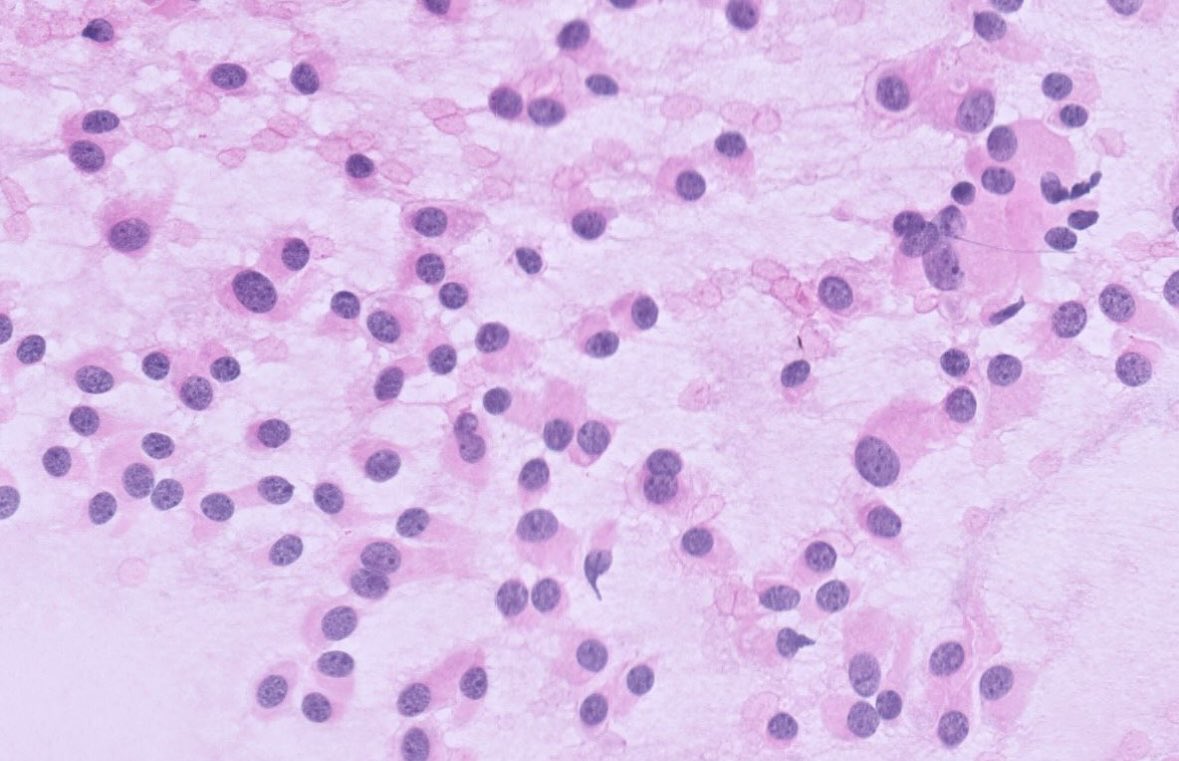

Peter Kobalka
@peterkobalka
Pathologist, teacher. Training and interests in neuropathology, cytopathology, thoracic, and general surgical pathology @OhioStatepath
ID: 1549840146278653952
20-07-2022 19:34:30
906 Tweet
481 Followers
181 Following






#GIPath #IDPath Brown Pathology and Laboratory Medicine A 60 year old man presents with perforated diverticulitis - with a curious finding in the serosal inflammation: Poll in reply.